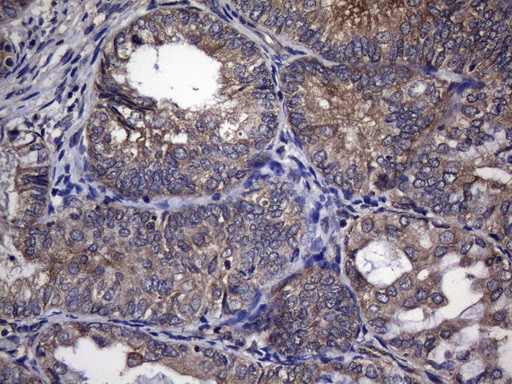
TRIM56 Antibody in Immunohistochemistry (Paraffin) (IHC (P))

Search
OriGene
TRIM56 Monoclonal Antibody (OTI8E12), TrueMAB™
{{$productOrderCtrl.translations['antibody.pdp.commerceCard.promotion.promotions']}}
{{$productOrderCtrl.translations['antibody.pdp.commerceCard.promotion.viewpromo']}}
{{$productOrderCtrl.translations['antibody.pdp.commerceCard.promotion.promocode']}}: {{promo.promoCode}} {{promo.promoTitle}} {{promo.promoDescription}}. {{$productOrderCtrl.translations['antibody.pdp.commerceCard.promotion.learnmore']}}
产品信息
TA808934
种属反应
宿主/亚型
分类
类型
克隆号
抗原
偶联物
形式
浓度
纯化类型
保存液
内含物
保存条件
运输条件
靶标信息
E3 ubiquitin-protein ligase that plays a key role in innate antiviral immunity (PubMed:21289118). In response to pathogen- and host-derived double-stranded DNA (dsDNA), targets STING1 to 'Lys-63'-linked ubiquitination, thereby promoting its homodimerization, a step required for the production of type I interferon IFN-beta. Independently of its E3 ubiquitin ligase activity, positive regulator of TLR3 signaling. Potentiates extracellular double stranded RNA (dsRNA)-induced expression of IFNB1 and interferon-stimulated genes ISG15, IFIT1/ISG56, CXCL10, OASL and CCL5/RANTES. Promotes establishment of an antiviral state by TLR3 ligand and TLR3-mediated chemokine induction following infection by hepatitis C virus (PubMed:22948160). [UniProt]
仅用于科研。不用于诊断过程。未经明确授权不得转售。
篇参考文献 (0)
生物信息学
蛋白别名: E3 ubiquitin-protein ligase TRIM56; RING finger protein 109; Tripartite motif-containing protein 56
基因别名: RNF109; TRIM56
UniProt ID: (Human) Q9BRZ2
Entrez Gene ID: (Human) 81844